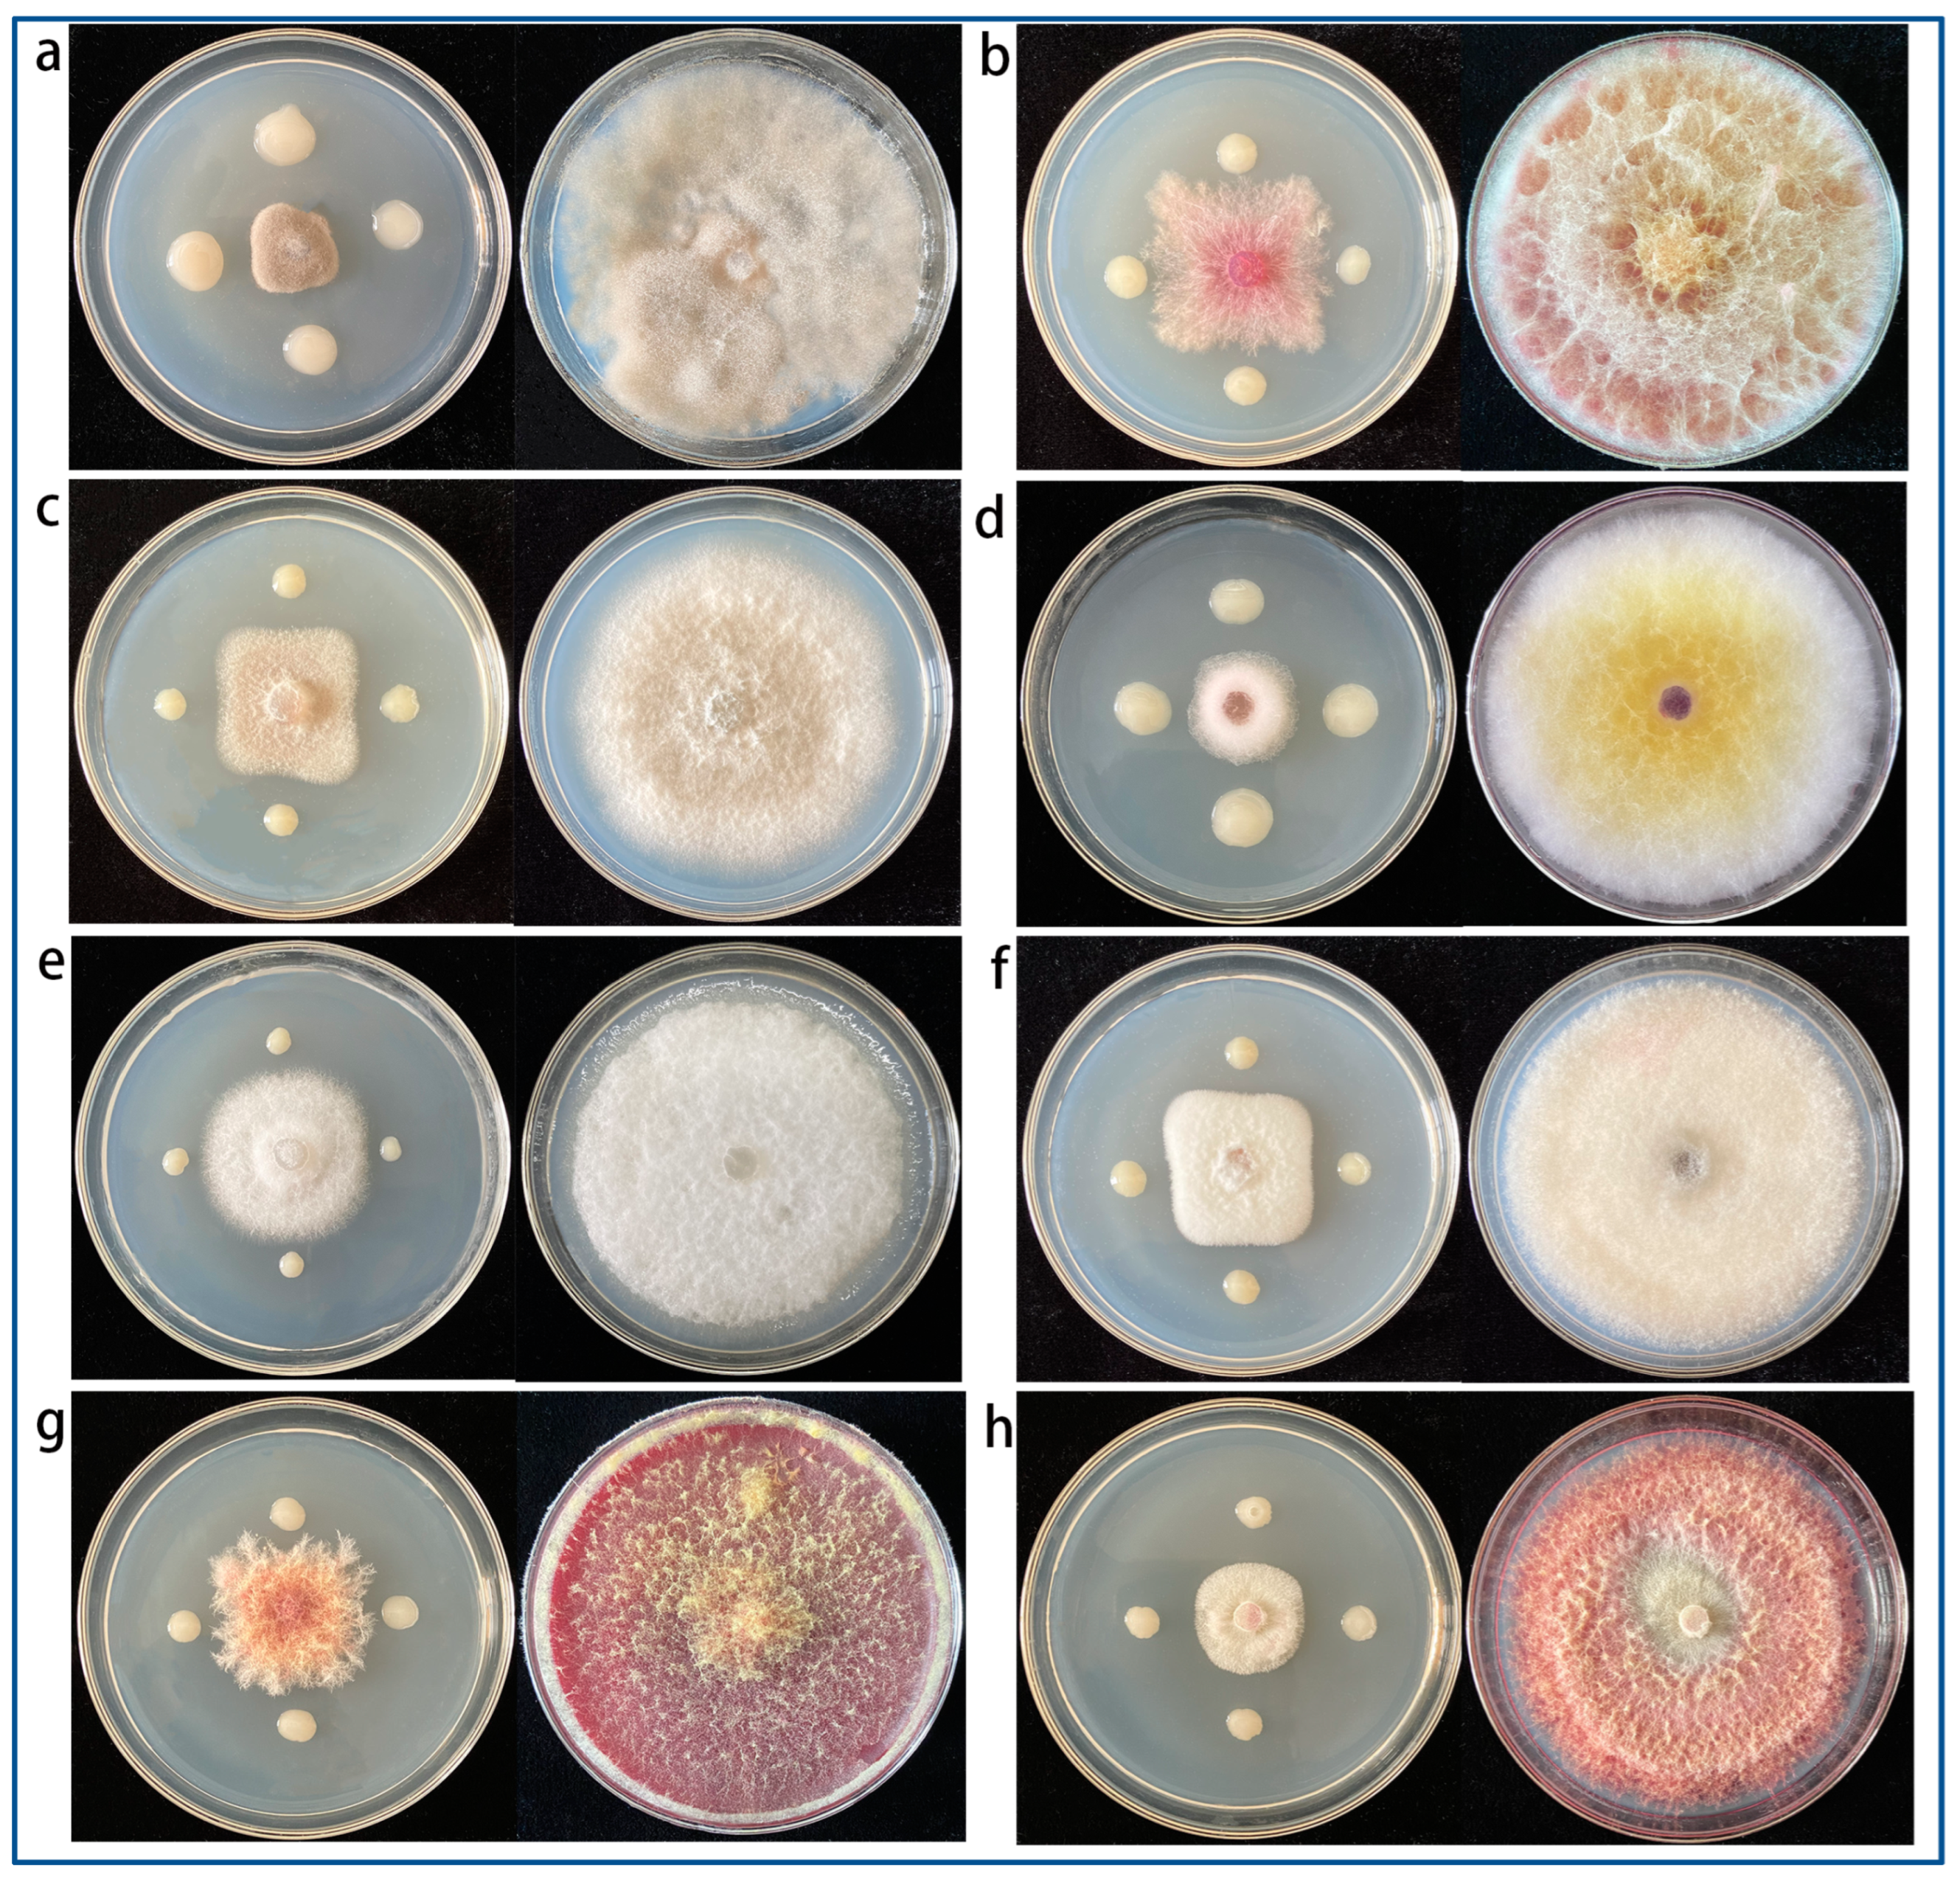
Agronomy 13 02437 g003

A Biocontrol Strain of Serratia plymuthica MM Promotes Growth and Controls Fusarium Wilt in Watermelon
Abstract
:1. Introduction
2. Materials and Methods
2.1. Isolation and Antagonism Test
2.2. Identification and Inhibition Spectrum of Isolate MM
2.3. Effect of MM on Spore Germination and Mycelial Morphology of FON
2.4. Detection of Growth-Promoting and Biological Control Traits
2.5. Growth-Promoting Effect of MM on Watermelon Seedlings
2.6. Colonization of MM in Watermelon Root
2.7. Effect of MM on Defense Enzyme Activity and Defense-Related Genes in Watermelon Seedlings
2.8. Identification of Active Components of MM by GC-MS
2.9. Control Effect of MM on Watermelon Fusarium wilt in the Pot Experiment
2.10. Statistical Analyses
3. Results
3.1. Isolation, Screening, and Identification of Antagonistic Bacteria against FON
3.2. Inhibition Spectrum of S. plymuthica MM
3.3. Effect of S. plymuthica MM on Mycelial Morphology and Spore Germination of FON
3.4. Estimation of Plant Growth-Promotion Substance and Extracellular Enzymes in MM
3.5. Colonization of S. plymuthica MM in Watermelon Root
3.6. Growth-Promotion Activity of S. plymuthica MM
3.7. Effect of S. plymuthica MM on the Activities of Defense-Related Enzyme
3.8. Effect of S. plymuthica MM on Resistance Gene Expression in Watermelon Plants
3.9. Identification of Bioactive Substances of S. plymuthica MM
3.10. Control effect of S. plymuthica MM on Watermelon Fusarium Wilt
4. Discussion
5. Conclusions
Supplementary Materials
Author Contributions
Funding
Data Availability Statement
Conflicts of Interest
References
- Miller, N.F.; Standish, J.R.; Quesada-Ocampo, L.M. Sensitivity of Fusarium oxysporum f. sp. niveum to Prothioconazole and Pydiflumetofen In Vitro and Efficacy for Fusarium Wilt Management in Watermelon. Plant Health Prog. 2020, 21, 13–18. [Google Scholar] [CrossRef]
- Kasote, D.M.; Jayaprakasha, G.K.; Singh, J.; Ong, K.; Crosby, K.M.; Patil, B.S. Metabolomics-based biomarkers of Fusarium wilt disease in watermelon plants. J. Plant Dis. Prot. 2020, 127, 591–596. [Google Scholar] [CrossRef]
- Devi, P.; Perkinsveazie, P.; Miles, C. Impact of Grafting on Watermelon Fruit Maturity and Quality. Horticulturae 2020, 6, 97. [Google Scholar] [CrossRef]
- Rahman, M.Z.; Ahmad, K.; Bashir Kutawa, A.; Siddiqui, Y.; Saad, N.; Geok Hun, T.; Hossain, M.I. Biology, Diversity, Detection and Management of Fusarium oxysporum f. sp. niveum Causing Vascular Wilt Disease of Watermelon (Citrullus lanatus): A Review. Agronomy 2021, 11, 1310. [Google Scholar] [CrossRef]
- Dong, X.M.; Lian, Q.G.; Chen, J.; Jia, R.M.; Zong, Z.F.; Ma, Q.; Wang, Y. The Improved Biocontrol Agent, F1-35, Protects Watermelon against Fusarium Wilt by Triggering Jasmonic Acid and Ethylene Pathways. Microorganisms 2022, 10, 1710. [Google Scholar] [CrossRef] [PubMed]
- González, V.; Armijos, E.; Garcés-Claver, A. Fungal endophytes as biocontrol agents against the main soil-borne diseases of melon and watermelon in Spain. Agronomy 2020, 10, 820. [Google Scholar] [CrossRef]
- Bustamante, M.I.; Elfar, K.; Eskalen, A. Evaluation of the Antifungal Activity of Endophytic and Rhizospheric Bacteria against Grapevine Trunk Pathogens. Microorganisms 2022, 10, 2035. [Google Scholar] [CrossRef]
- Abo-Elyousr, K.A.M.; Saad, M.M.; Al-Qurashi, A.D.; Ibrahim, O.H.M.; Mousa, M.A.A. Management of Cumin Wilt Caused by Fusarium oxysporum Using Native Endophytic Bacteria. Agronomy 2022, 12, 2510. [Google Scholar] [CrossRef]
- Samaras, A.; Roumeliotis, E.; Ntasiou, P.; Karaoglanidis, G. Bacillus subtilis MBI600 promotes growth of tomato plantsand induces systemic resistance contributing to the control of soilborne pathogens. Plants 2021, 10, 1113. [Google Scholar] [CrossRef]
- Ahmed, W.; Zhou, G.; Yang, J.; Munir, S.; Ahmed, A.; Liu, Q.; Ji, G. Bacillus amyloliquefaciens WS-10 as a potential plant growth-promoter and biocontrol agent for bacterial wilt disease of flue-cured tobacco. Egypt. J. Biol. Pest Control. 2022, 32, 25. [Google Scholar] [CrossRef]
- Platel, R.; Sawicki, M.; Esmaeel, Q.; Randoux, B.; Trapet, P.; El Guilli, M.; Chtaina, N.; Arnauld, S.; Bricout, A.; Rochex, A.; et al. Isolation and Identifification of Lipopeptide-Producing Bacillus velezensis Strains from Wheat Phyllosphere with Antifungal Activity against the Wheat Pathogen Zymoseptoria tritici. Agronomy 2022, 12, 95. [Google Scholar] [CrossRef]
- Xu, W.; Wang, K.; Wang, H.; Liu, Z.; Shi, Y.; Gao, Z.; Wang, Z. Evaluation of the biocontrol potential of Bacillus sp. WB against Fusarium oxysporum f. sp. niveum. Biol. Control 2020, 147, 104288. [Google Scholar] [CrossRef]
- Zhang, Y.; Xiao, J.L.; Yang, K.; Wang, Y.Q.; Tian, Y.; Liang, Z.H. Transcriptomic and metabonomic insights into the biocontrol mechanism of Trichoderma asperellum M45a against watermelon Fusarium wilt. PLoS ONE 2022, 17, e0272702. [Google Scholar] [CrossRef] [PubMed]
- Czajkowski, R.; vander Wolf, J.M. Draft genome sequence of the biocontrol strain Serratia plymuthica A30, isolated from rotting potato tuber tissue. J. Bacteriol. 2012, 194, 6999–7000. [Google Scholar] [CrossRef]
- Barbé, S.; Figàs-Segura, À.; Benada, M.H.; Navarro-Herrero, I.; Sampaio, T.M.; Biosca, E.G.; Marco-Noales, E. Plant-associated microbiota as a source of antagonistic bacteria against the phytopathogen Erwinia amylovora. Environ. Microbiol. Rep. 2022, 14, 559–569. [Google Scholar] [CrossRef]
- Hadizadeh, I.; Peivastegan, B.; Hannukkala, A.; Van der Wolf, J.M.; Nissinen, R.; Pirhonen, M. Biological control of potato soft rot caused by Dickeya solani and the survival of bacterial antagonists under cold storage conditions. Plant Pathol. 2019, 68, 297–311. [Google Scholar] [CrossRef]
- Nguyen, H.T.; Kim, H.G.; Yu, N.H.; Hwang, I.M.; Kim, H.; Kim, Y.C.; Kim, J.C. In vitro and in vivo antibacterial activity of serratamid, a novel peptide–polyketide antibiotic isolated from Serratia plymuthica C1, against phytopathogenic bacteria. J. Agric. Food Chem. 2021, 69, 5471–5480. [Google Scholar] [CrossRef]
- Schmidt, R.; Jager, V.D.; Zühlke, D.; Wolff, C.; Bernhardt, J.; Cankar, K.; Beekwilder, J.; van Ijcken, W.; Sleutels, F.; de Boer, W.; et al. Fungal volatile compounds induce production of the secondary metabolite sodorifen in Serratia plymuthica PRI-2C. Sci. Rep. 2017, 7, 862. [Google Scholar] [CrossRef]
- Apridiana, I.; Aisyah, S.N.; Oktavioni, M.; Fatiah, R.; Hourssari, J. The culture medium optimization of Serratia plymuthica UBCF_13 to produce antifungal compounds. IOP Conf. Ser. Earth Environ. Sci. 2021, 741, 12062. [Google Scholar] [CrossRef]
- Proença, D.N.; Schwab, S.; Vidal, M.S.; Baldani, J.I.; Xavier, G.R.; Morais, P.V. The nematicide Serratia plymuthica M24T3 colonizes Arabidopsis thaliana, stimulates plant growth, and presents plant beneficial potential. Braz. J. Microbiol. 2019, 50, 777–789. [Google Scholar] [CrossRef]
- Zheng, T.W.; Liu, L.; Nie, Q.W.; Hsiang, T.; Sun, Z.X.; Zhou, Y. Isolation, identification and biocontrol mechanisms of endophytic bacterium D61-A from Fraxinus hupehensis against Rhizoctonia solani. Biol. Control 2021, 158, 104621. [Google Scholar] [CrossRef]
- Li, Z.Y.; Li, J.J.; Yu, M.; Quandahor, P.; Tian, T.; Shen, T. Bacillus velezensis FX-6 suppresses the infection of Botrytis cinerea and increases the biomass of tomato plants. PLoS ONE 2023, 18, e0286971. [Google Scholar] [CrossRef] [PubMed]
- Zhao, Z.M.; Shang, X.F.; Lawoe, R.K.; Liu, Y.Q.; Zhou, R.; Sun, Y.; Yan, Y.F.; Li, J.C.; Yang, G.Z.; Yang, C.J. Anti-phytopathogenic activity and the possible mechanisms of action of isoquinoline alkaloid sanguinarine. Pestic. Biochem. Physiol. 2019, 159, 51–58. [Google Scholar] [CrossRef]
- Xu, W.; Yang, Q.; Yang, F.; Xie, X.; Goodwin, P.H.; Deng, X.X.; Tian, B.M.; Yang, L.Y. Evaluation and genome analysis of Bacillus subtilis YB-04 as a potential biocontrol agent against Fusarium wilt and growth promotion agent of Cucumber. Front. Microbiol. 2022, 13, 885430. [Google Scholar] [CrossRef] [PubMed]
- Khedher, S.B.; Mejdoub-Trabelsi, B.; Tounsi, S. Biological potential of Bacillus subtilis V26 for the control of Fusarium wilt and tuber dry rot on potato caused by Fusarium species and the promotion of plant growth. Biol. Control 2021, 152, 104444. [Google Scholar] [CrossRef]
- Domanskaya, O.V.; Bome, N.A.; Iashnikov, A.V.; Vasilchenko, A.V.; Vasilchenko, A.S. The Multiple Activities and the Plant Benefificial Potential of Bacillus spp. Derived from the Permafrost of Western Siberia. Agronomy 2021, 11, 2347. [Google Scholar] [CrossRef]
- Abdallah, D.B.; Frikha-Gargouri, O.; Tounsi, S. Rizhospheric competence, plant growth promotion and biocontrol efficacy of Bacillus amyloliquefaciens subsp. plantarum strain 32a. Biol. Control 2018, 124, 61–67. [Google Scholar] [CrossRef]
- Xiong, Q.; Liu, D.; Zhang, H.; Dong, X.; Zhang, G.; Liu, Y.; Zhang, R. Quorum Sensing Signal Autoinducer-2 Promotes Root Colonization of Bacillus velezensis SQR9 by Affecting Biofifilm Formation and Motility. Appl. Microbiol. Biotechnol. 2020, 104, 7177–7185. [Google Scholar] [CrossRef]
- Zhang, Z.; Zhang, W.; Wang, X.; Kou, Z.; Wang, Y.; Islam, R.; Zhang, J.; Liu, L.; Shen, T.; Tian, Y. Isolation and identification of antagonistic bacteria of Angelica root rot and their mechanism as biological control. Biol. Control 2022, 177, 105120. [Google Scholar] [CrossRef]
- Saha, S.; Begum, H.H.; Nasrin, S.; Samad, R. Effects of drought stress on pigment and protein contents and antioxidant enzyme activities in five varieties of rice (Oryza sativa L.). Bangladesh J. Bot. 2020, 49, 997–1002. [Google Scholar] [CrossRef]
- Abdelkhalek, A.; Behiry, S.I.; Al-Askar, A.A. Bacillus velezensis PEA1 inhibits Fusarium oxysporum growth and induces systemic resistance to cucumber mosaic virus. Agronomy 2020, 10, 1312. [Google Scholar] [CrossRef]
- Noman, M.; Ahmed, T.; Ijaz, U.; Shahid, M.; Nazir, M.M.; White, J.C.; Li, D.Y.; Song, F.M. Bio-functionalized manganese nanoparticles suppress Fusarium wilt in watermelon (Citrullus lanatus L.) by infection disruption, host defense response potentiation, and soil microbial community modulation. Small 2023, 19, 2205687. [Google Scholar] [CrossRef] [PubMed]
- Hartmann, A.; Proença, D.N. Biological Control of Phytopathogens: Mechanisms and Applications. Pathogens 2023, 12, 783. [Google Scholar] [CrossRef]
- Leonardi, G.R.; Polizzi, G.; Vitale, A.; Aiello, D. Effificacy of Biological Control Agents and Resistance Inducer for Control of Mal Secco Disease. Plants 2023, 12, 1735. [Google Scholar] [CrossRef] [PubMed]
- Lahlali, R.; Ezrari, S.; Radouane, N.; Kenfaoui, J.; Esmaeel, Q.; El Hamss, H.; Belabess, Z.; Barka, E.A. Biological Control of Plant Pathogens: A Global Perspective. Microorganisms 2022, 10, 596. [Google Scholar] [CrossRef] [PubMed]
- Hua, G.K.H.; Wang, L.; Chen, J.; Ji, P. Biological control of Fusarium wilt on watermelon by Fluorescent pseudomonads. Biocontrol. Sci. Technol. 2020, 30, 212–227. [Google Scholar] [CrossRef]
- Zhu, J.; Tan, T.; Shen, A.; Yang, X.; Yu, Y.; Gao, C.; Li, Z.; Cheng, Y.; Chen, J.; Guo, L.; et al. Biocontrol potential of Bacillus subtilis IBFCBF-4 against Fusarium wilt of watermelon. J. Plant Pathol. 2020, 102, 433–441. [Google Scholar] [CrossRef]
- Jiang, C.H.; Yao, X.F.; Mi, D.D.; Li, Z.J.; Yang, B.Y.; Zheng, Y.; Qi, Y.J.; Guo, J.H. Comparative transcriptome analysis reveals the biocontrol mechanism of Bacillus velezensis F21 against Fusarium wilt on watermelon. Front. Microbiol. 2019, 10, 652. [Google Scholar] [CrossRef]
- Dong, X.; Tu, C.; Xie, Z.; Luo, Y.; Zhang, L.; Li, Z. The Genome of Bacillus velezensis SC60 Provides Evidence for Its Plant Probiotic Effects. Microorganisms 2022, 10, 767. [Google Scholar] [CrossRef]
- Wang, X.; Zhou, X.; Cai, Z.; Guo, L.; Chen, X.; Chen, X.; Liu, J.; Feng, M.; Qiu, Y.; Zhang, Y.; et al. A biocontrol strain of Pseudomonas aeruginosa CQ-40 promote growth and control Botrytis cinerea in tomato. Pathogens 2020, 10, 22. [Google Scholar] [CrossRef]
- Lobo, L.L.B.; de Andrade da Silva, M.S.R.; Castellane, T.C.L.; Carvalho, R.F.; Rigobelo, E.C. Effect of Indole-3-Acetic Acid on Tomato Plant Growth. Microorganisms 2022, 10, 2212. [Google Scholar] [CrossRef] [PubMed]
- Timofeeva, A.M.; Galyamova, M.R.; Sedykh, S.E. Bacterial Siderophores: Classifification, Biosynthesis, Perspectives of Use in Agriculture. Plants 2022, 11, 3065. [Google Scholar] [CrossRef] [PubMed]
- Dai, J.; Dong, A.; Xiong, G.; Liu, Y.; Hossain, S.; Liu, S.; Gao, N.; Li, S.; Wang, J.; Qiu, D. Production of highly active extracellular amylase and cellulase from Bacillus subtilis ZIM3 and a recombinant strain with a potential application in tobacco fermentation. Front. Microbiol. 2020, 11, 1539. [Google Scholar] [CrossRef] [PubMed]
- Mesele Admassie, M.; Woldehawariat, Y.; Alemu, T. In Vitro Evaluation of Extracellular Enzyme Activity and Its Biocontrol Efficacy of Bacterial Isolates from Pepper Plants for the Management of Phytophthora capsici. BioMed Res. Int. 2022, 2022, 6778352. [Google Scholar] [CrossRef]
- Li, Z.; Ye, X.; Liu, M.; Xia, C.; Zhang, L.; Luo, X.; Wang, T.; Chen, Y.; Zhao, Y.; Qiao, Y.; et al. A novel outer membrane β-1, 6-glucanase is deployed in the predation of fungi by myxobacteria. ISME J. 2019, 13, 2223–2235. [Google Scholar] [CrossRef]
- El-Sharkawy, E.; Abdalla, M.Y.; El-Shemy, A.O. Biological control and induction of systemic resistance against cucumber Fusarium wilt by plant growth promoting rhizo-organisms. Egypt. J. Biol. Pest Control 2015, 25, 407–413. [Google Scholar]
- Kaari, M.; Joseph, J.; Manikkam, R.; Sreenivasan, A.; Venugopal, G.; Alexander, B.; Krishnan, S. Biocontrol streptomyces induces resistance to bacterial wilt by increasing defense-related enzyme activity in solanum melongena L. Curr. Microbiol. 2022, 79, 146. [Google Scholar] [CrossRef]
- Lü, G.Y.; Guo, S.G.; Zhang, H.Y.; Geng, L.H.; Song, F.M.; Fei, Z.J.; Xu, Y. Transcriptional profiling of watermelon during its incompatible interaction with Fusarium oxysporum f. sp. niveum. Eur. J. Plant Pathol. 2011, 131, 585–601. [Google Scholar] [CrossRef]
- Sa, R.B.; Zhang, J.L.; Sun, J.Z.; Gao, Y.X. Colonization characteristics of poplar fungal disease biocontrol bacteria N6-34 and the inhibitory effect on pathogenic fungi by real-time fluorescence quantitative PCR detection. Curr. Microbiol. 2021, 78, 2916–2925. [Google Scholar] [CrossRef]
- Li, C.-X.; Fu, X.-P.; Zhou, X.-G.; Liu, S.-W.; Xia, Y.; Li, N.-H.; Zhang, X.-X.; Wu, F.-Z. Treatment with wheat root exudates and soil microorganisms from wheat/watermelon companion cropping can induce watermelon disease resistance against Fusarium oxysporum f. sp. niveum. Plant Dis. 2019, 103, 1693–1702. [Google Scholar] [CrossRef]
- Zhu, F.Y.; Fang, Y.; Wang, Z.W.; Wang, P.; Yang, K.K.; Xiao, L.T.; Wang, R.Z. Salicylic acid remodeling of the rhizosphere microbiome induces watermelon root resistance against Fusarium oxysporum f. sp. niveum infection. Front. Microbiol. 2022, 13, 1015038. [Google Scholar] [CrossRef] [PubMed]
- Xie, S.S.; Jiang, H.Y.; Ding, T.; Xu, Q.Q.; Chai, W.B.; Cheng, B.J. Bacillus amyloliquefaciens FZB42 represses plant miR846 to induce systemic resistance via a jasmonic acid-dependent signalling pathway. Mol. Plant Pathol. 2018, 19, 1612–1623. [Google Scholar] [CrossRef] [PubMed]
- Pazarlar, S.; Madriz-Ordeñana, K.; Thordal-Christensen, H. Bacillus cereus EC9 protects tomato against Fusarium wilt through JA/ET-activated immunity. Front. Plant Sci. 2022, 13, 1090947. [Google Scholar] [CrossRef]
- Wang, X.L.; Yuan, Z.X.; Shi, Y.Q.; Cai, F.H.; Zhao, J.R.; Wang, J.Z.; Wang, Y.P. Bacillus amyloliquefaciens HG01 induces resistance in loquats against anthracnose rot caused by Colletotrichum acutatum. Postharvest Biol. Technol. 2020, 160, 111034. [Google Scholar] [CrossRef]
- John, J.; Mallikarjunaswamy, G.E.; Noushad, N. Probiotic rhizospheric Bacillus sp. from Zingiber officinale Rosc. displays antifungal activity against soft rot pathogen Pythium sp. Curr. Plant Biol. 2021, 27, 100217. [Google Scholar] [CrossRef]
- Abdelkhalek, A.; Aseel, D.G.; Király, L.; Künstler, A.; Moawad, H.; Al-Askar, A.A. Induction of Systemic Resistance to Tobacco mosaic virus in Tomato through Foliar Application of Bacillus amyloliquefaciens Strain TBorg1 Culture Filtrate. Viruses 2022, 14, 1830. [Google Scholar] [CrossRef]
- Maulidia, V.; Sriwati, R.; Soesanto, L.; Syamsuddin; Hamaguchi, T.; Hasegawa, K. Endophytic bacteria isolated from higher plant in Aceh, Indonesia, and their chemical compounds activity against Fusarium oxysporum f. sp. lycopersici. Egypt J. Biol. Pest Control 2021, 31, 31. [Google Scholar] [CrossRef]
- Abd El-Hameed, R.H.; Sayed, A.I.; Mahmoud Ali, S.; Mosa, M.A.; Khoder, Z.M.; Fatahala, S.S. Synthesis of novel pyrroles and fused pyrroles as antifungal and antibacterial agents. J. Enzyme Inhib. Med. Chem. 2021, 36, 2183–2198. [Google Scholar] [CrossRef]
- Rashad, Y.M.; Abdalla, S.A.; Sleem, M.M. Endophytic Bacillus subtilis SR22 Triggers Defense Responses in Tomato against Rhizoctonia Root Rot. Plants 2022, 11, 2051. [Google Scholar] [CrossRef]
- Awan, Z.A.; Shoaib, A.; Schenk, P.M.; Ahmad, A.; Alansi, S.; Paray, B.A. Antifungal potential of volatiles produced by Bacillus subtilis BS-01 against Alternaria solani in Solanum lycopersicum. Front. Plant Sci. 2023, 13, 1089562. [Google Scholar] [CrossRef]
- Li, X.J.; Zhang, M.Y.; Qi, D.F.; Zhou, D.B.; Qi, C.L.; Li, C.Y.; Liu, S.W.; Xiang, D.D.; Zhang, L.; Xie, J.H.; et al. Biocontrol Ability and Mechanism of a Broad-Spectrum Antifungal Strain Bacillus safensis sp. QN1NO-4 Against Strawberry Anthracnose Caused by Colletotrichum fragariae. Front. Microbiol. 2021, 12, 735732. [Google Scholar] [CrossRef] [PubMed]
- Abdelkhalek, A.; Al-Askar, A.A.; Elbeaino, T.; Moawad, H.; El-Gendi, H. Protective and Curative Activities of Paenibacillus polymyxa against Zucchini yellow mosaic virus Infestation in Squash Plants. Biology 2022, 11, 1150. [Google Scholar] [CrossRef] [PubMed]
- Heo, A.Y.; Koo, Y.M.; Choi, H.W. Biological Control Activity of Plant Growth Promoting Rhizobacteria Burkholderia contaminans AY001 against Tomato Fusarium Wilt and Bacterial Speck Diseases. Biology 2022, 11, 619. [Google Scholar] [CrossRef] [PubMed]
- Zaman, N.R.; Chowdhury, U.F.; Reza, R.N.; Chowdhury, F.T.; Sarker, M.; Hossain, M.M.; Akbor, A.; Amin, A.; Islam, M.R.; Khan, H. Plant growth promoting endophyte Burkholderia contaminans NZ antagonizes phytopathogen Macrophomina phaseolina through melanin synthesis and pyrrolnitrin inhibition. PLoS ONE 2021, 16, e0257863. [Google Scholar] [CrossRef]

| Phytopathogen | Plant Disease | Treatment Colony Diameter (cm) | Control Colony Diameter (cm) | Inhibition Ratio (%) |
|---|---|---|---|---|
| Botrytis cinerea | Gray mold of strawberry | 2.04 ± 0.075 | 7.83 ± 0.019 | 74.00 a |
| Fusarium graminearum | Wheat scab | 3.28 ± 0.029 | 8.41 ± 0.052 | 60.96 c |
| Colletotrichum gloeosporioides penz | Lycium barbarum Anthrax | 2.86 ± 0.126 | 8.05 ± 0.018 | 64.38 b |
| Fusarium proliferatum | Rice panicle rot | 3.17 ± 0.078 | 8.51 ± 0.003 | 62.69 c |
| Fusarium oxysporum | Fusarium wilt of cotton | 2.64 ± 0.039 | 8.16 ± 0.021 | 67.64 b |
| Fusarium moniliforme | Fusarium wilt of lily | 2.82 ± 0.058 | 8.08 ± 0.008 | 65.13 b |
| Fusarium solani | Root rot of Astragalus membranaceus | 2.73 ± 0.029 | 8.51 ± 0.019 | 67.90 b |
| Fusarium avenaceum | Root rot of Angelica sinensis | 3.07 ± 0.029 | 8.52 ± 0.005 | 63.99 bc |
| Retention Time (min) | Compounds | Area % | Chemical Formula | Molecular Weight (g/mol) |
|---|---|---|---|---|
| 21.26 | 2,5-Piperazinedione, 3-methyl-6-(1-methylethyl)- | 0.42 | C8H14N2O2 | 170.21 |
| 22.77 | Pyrrolo[1,2-a]pyrazine-1,4-dione, hexahydro- | 2.98 | C7H10N2O2 | 154.17 |
| 23.55 | Pyrrolo[1,2-a]pyrazine-1,4-dione,hexahydro-3-(2-methylpropyl)- | 1.16 | C11H18N2O2 | 210.28 |
| 26.50 | 2,5-Piperazinedione, 3,6-bis(2-methylpropyl)- | 1.07 | C12H22N2O2 | 226.32 |
| 30.52 | 9-Octadecenamide, (Z)- | 3.45 | C18H35NO | 281.48 |
| Treatment | Disease Index | Control Efficacy (%) |
|---|---|---|
| FON | 90.00 ± 0.08 a | - |
| FON + MM | 23.33 ± 0.02 b | 74.07 a |
| FON + Hymexazol | 21.67 ± 0.04 b | 75.92 a |
Disclaimer/Publisher’s Note: The statements, opinions and data contained in all publications are solely those of the individual author(s) and contributor(s) and not of MDPI and/or the editor(s). MDPI and/or the editor(s) disclaim responsibility for any injury to people or property resulting from any ideas, methods, instructions or products referred to in the content. |
© 2023 by the authors. Licensee MDPI, Basel, Switzerland. This article is an open access article distributed under the terms and conditions of the Creative Commons Attribution (CC BY) license (https://creativecommons.org/licenses/by/4.0/).
Share and Cite
Li, Z.; Ma, J.; Li, J.; Chen, Y.; Xie, Z.; Tian, Y.; Su, X.; Tian, T.; Shen, T. A Biocontrol Strain of Serratia plymuthica MM Promotes Growth and Controls Fusarium Wilt in Watermelon. Agronomy 2023, 13, 2437. https://doi.org/10.3390/agronomy13092437
Li Z, Ma J, Li J, Chen Y, Xie Z, Tian Y, Su X, Tian T, Shen T. A Biocontrol Strain of Serratia plymuthica MM Promotes Growth and Controls Fusarium Wilt in Watermelon. Agronomy. 2023; 13(9):2437. https://doi.org/10.3390/agronomy13092437
Chicago/Turabian StyleLi, Zhaoyu, Jinxiu Ma, Jiajia Li, Yinglong Chen, Zhihong Xie, Yongqiang Tian, Xu Su, Tian Tian, and Tong Shen. 2023. "A Biocontrol Strain of Serratia plymuthica MM Promotes Growth and Controls Fusarium Wilt in Watermelon" Agronomy 13, no. 9: 2437. https://doi.org/10.3390/agronomy13092437







